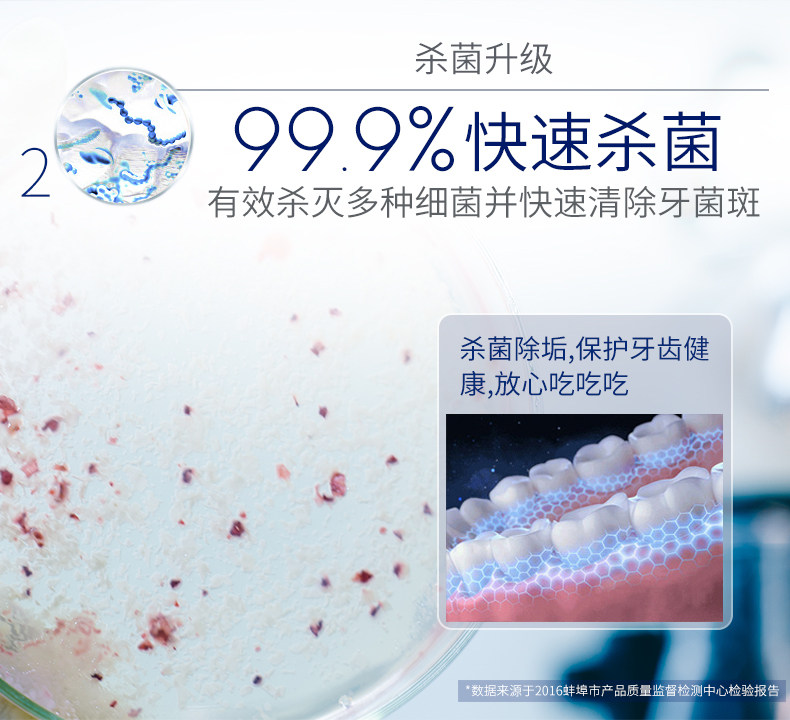

Ортодонтические гигиенические двухэтажные ортезы для брекетов, моющее средство, 72 штук

Цена: 3 085руб. (¥146)
Артикул: 521645804139
Вес товара: ~0.7 кг. Указан усредненный вес, который может отличаться от фактического. Не включен в цену, оплачивается при получении.
Описание товараPGRpdj48aW1nIHNyYz0iaHR0cHM6Ly9pbWcuYWxpY2RuLmNvbS9pbWdleHRyYS9pMi8yMTMxNTg0NTI0L1RCMkRaYXBsOXRZQmVOalNzcGtYWGJVOFZYYV8hITIxMzE1ODQ1MjQuanBnIj48L2Rpdj48ZGl2PjxpbWcgc3JjPSJodHRwczovL2ltZy5hbGljZG4uY29tL2ltZ2V4dHJhL2kyLzIxMzE1ODQ1MjQvVEIyWnppbmRid3JCS05qU1pQY1hYWHBhcFhhXyEhMjEzMTU4NDUyNC5qcGciPjwvZGl2PjxkaXY+PGltZyBzcmM9Imh0dHBzOi8vaW1nLmFsaWNkbi5jb20vaW1nZXh0cmEvaTMvMjEzMTU4NDUyNC9UQjI5V3B5bDRXWUJ1Tmp5MXprWFhYR0dwWGFfISEyMTMxNTg0NTI0LmpwZyI+PC9kaXY+PGRpdj48aW1nIHNyYz0iaHR0cHM6Ly9pbWcuYWxpY2RuLmNvbS9pbWdleHRyYS9pMS8yMTMxNTg0NTI0L1RCMm1VaV9kaU1uQktOalNaRm9YWGJPU0ZYYV8hITIxMzE1ODQ1MjQuanBnIj48L2Rpdj48ZGl2PjxpbWcgc3JjPSJodHRwczovL2ltZy5hbGljZG4uY29tL2ltZ2V4dHJhL2kzLzIxMzE1ODQ1MjQvVEIycmRjU2xGdVdCdU5qU3N6YlhYY1M3RlhhXyEhMjEzMTU4NDUyNC5qcGciPjwvZGl2PjxkaXY+PGltZyBzcmM9Imh0dHBzOi8vaW1nLmFsaWNkbi5jb20vaW1nZXh0cmEvaTMvMjEzMTU4NDUyNC9UQjI4cVBLWFh5WkJ1Tmp0X2pKWFhiRGxYWGFfISEyMTMxNTg0NTI0LmpwZyI+PC9kaXY+PGRpdj48aW1nIHNyYz0iaHR0cHM6Ly9pbWcuYWxpY2RuLmNvbS9pbWdleHRyYS9pMy8yMTMxNTg0NTI0L1RCMmJucGFsN3lXQnVOankwRnBYWGFzc1hYYV8hITIxMzE1ODQ1MjQuanBnIj48L2Rpdj48ZGl2PjxpbWcgc3JjPSJodHRwczovL2ltZy5hbGljZG4uY29tL2ltZ2V4dHJhL2kzLzIxMzE1ODQ1MjQvVEIyUURwYWw3eVdCdU5qeTBGcFhYYXNzWFhhXyEhMjEzMTU4NDUyNC5qcGciPjwvZGl2PjxkaXY+PGltZyBzcmM9Imh0dHBzOi8vaW1nLmFsaWNkbi5jb20vaW1nZXh0cmEvaTQvMjEzMTU4NDUyNC9UQjJQdVZvbFkxWUJ1TmpTc3poWFhjVXNGWGFfISEyMTMxNTg0NTI0LmpwZyI+PC9kaXY+
Продавец:牙齿医生家加盟店
Рейтинг:

Всего отзывов:0
Положительных:0
Добавить в корзину
- Информация о товаре
- Фотографии